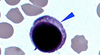
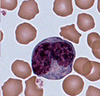
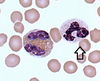

דם Flashcards
(27 cards)
פאגוציטוזה - משמעות
יכולת בולענות של פתוגנים בתא
תאי דם לבנים פאגוציטוזיים
ניוטרופיל, מונוציט, אאזנופיל
לימפוציט:
גודל 6-8 ננומטר, גרעין מוגדל ועגול
מונוציט:
גודל 9-12 ננומטר, גרעין בצורת פרסה, גולג’י לבן עמום
ניוטרופיל:
גודל 7-9 ננומטר, גרעין אמורפי של 3-5 אונות מחוברות, ניתן להבחין בקושי בגרנולות

אאוזינופיל:
גודל 9-10 ננומטר, גרעין ברור של 2 אונות, גרנולות צבועות בגודל אחיד

באזופיל:
גודל 7-9 ננומטר, גרעין אי-רגולרי ואמורפי של שני חלקים עיקריים וייתכנו עוד, גרנולות עגולות בגדלים משתנים ומטשטשות את הגרעין
תאים אגרנולריים
לימפוציטים, מונוציטים
תאים גרנולריים
אאזנופיל, בזופיל, ניוטרופיל

אריתרוציטים:
גודל 8 ננומטר, אין גרעין בתא, נצבעים באדום באופן אחיד (נראים כמו דיסק), ומרוכזים בשרשראות

תרומבוציטים:
חתיכות תאים גדולים ממח העצם, אין גרעין או אורגנלות, מופיעות לרוב קשורות בקבוצות
גודל לויקוציטים גרנולריים
בזופילים: 7-9 ננומטר
נטורופילים: 7-9 ננומטר
אאוזנופילים: 9-10 ננומטר
תפקיד לימפוציטים
תקיפת גופים זרים באזורים לימפואידים משניים כמו טחול, שקדים ובלוטות לימפה
תפקיד מונוציטים
עוברים בקלות דרך כלי דם, מפרישים רעלנים בו, וחודרים לרקמות והופכים למאקרופאג’ים בלעניים. מעורבים בדלקות כרוניות
תפקיד בזופיל
משחרר הפרין, סרוטונין והיסטמין אשר אצורים בגרנולות שלו, בכדי לטפל בפתוגן
תפקיד ניוטרופיל
פעיל ביותר, משמש כקו הגנה ראשון, מבצע בליעה כנגד חיידקים לרוב
תפקיד אאוזינופיל
הורס טפילים בעזרת בולענות או מדכא תגובות אלרגיות
(סוגי הרקמות (4
אפיתל , שריר, עצבים, רקמת חיבור
מרכיבי הדם ומינון
פלסמה 55%
תאי דם לבנים 1%
תאי דם אדומים 45%
חלוקת הלויקוציטים
לימפוציטים: 20%-35%
מונוציטים: 3%-8%
ניוטרופיל: 65%-75%
אאוזנופיל: 2%-4%
בזופיל: 0.5%-1.5%
מאקרופאג’
מונוציט שעבר פאגוציטוזה ומסוגל לבלוע חיידקים
טרומבוציטים - תפקיד
קרישה של הדם
אריתרוציטים - תפקיד
העברת גזים: חמצן ופחמן דו חמצני
גודל לויקוציטים אגרנולריים
לימפוציטים: 6-8 ננומטר
מונוציטים: 9-12 ננומטר